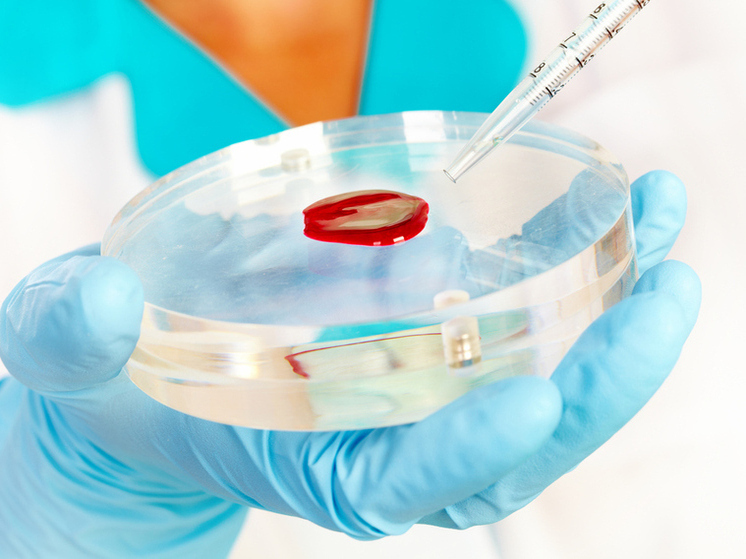
В Котласе лабораторно подтвердили случаи гонконгского гриппа

В Котласской центральной городской больнице зафиксированы два случая заражения гриппом А (H3N2), известным как гонконгский. Заболевшими оказались двое детей, пишет ИА «Регион 29».
Как сообщили в медучреждении, отличительными признаками этого штамма являются острое начало, высокая температура, сильная слабость и интоксикация. Заболевание представляет особую опасность для детей до года и пожилых людей с хроническими патологиями, так как может вызывать серьёзные осложнения, включая пневмонию. Надежной защитой медики называют своевременную вакцинацию, отметив, что все актуальные в этом сезоне вакцины содержат компонент против вируса H3N2.
На фоне роста заболеваемости в больнице уже введены ограничения. Посещения пациентов теперь возможны только по согласованию с лечащим врачом. За минувшую неделю в Котласе также было выявлено около тысячи случаев ОРВИ, большинство из которых — среди детей.
Жителям области рекомендуют соблюдать профилактические меры: чаще мыть руки, проветривать помещения и включать в рацион продукты, богатые витамином С. При появлении симптомов необходимо сразу обращаться за медицинской помощью.